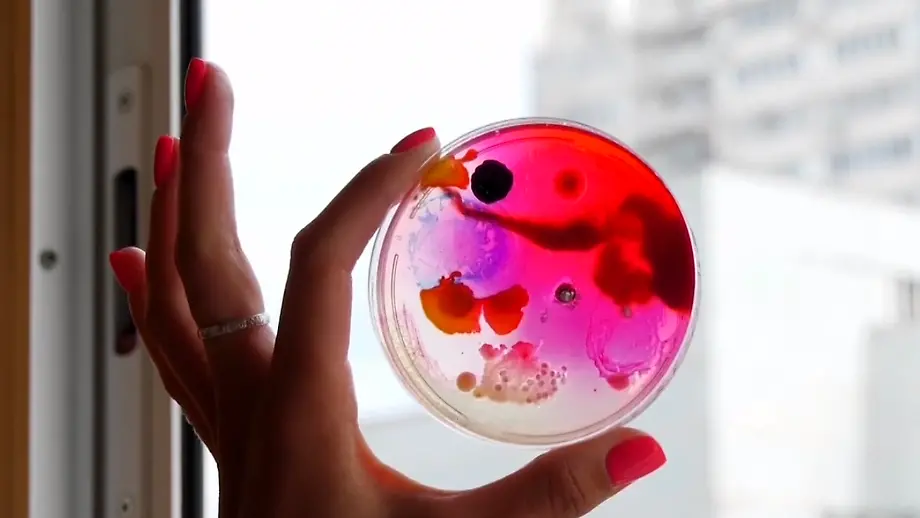
Video poster

Video
Von wegen unappetitlichRussin kreiert einzigartige Schimmel-Kunstwerke
18.05.2021, 19:04 UhrFür die meisten ist Schimmel eine unliebsame Erscheinung auf verdorbenem Essen oder an der feuchten Hauswand. Nicht für Daria Fedorova. Die Moskauer Kunststudentin sammelt gezielt Schimmelsporen und erschafft daraus visuelle Kunstwerke in Petrischalen.
Topvideos